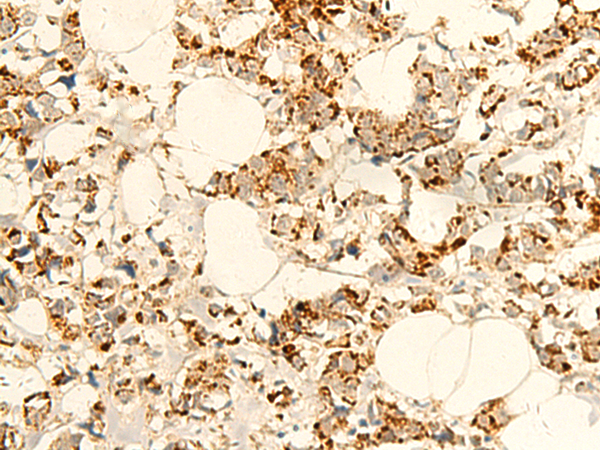

中文名稱: 兔抗NAPRT多克隆抗體
英文名稱: Anti-NAPRT rabbit polyclonal antibody
別 名: nicotinate phosphoribosyltransferase; NAPRT1; PP3856
相關(guān)類別: 一抗
儲(chǔ) 存: 冷凍(-20℃)
宿 主: Rabbit
抗 原: NAPRT
反應(yīng)種屬: Human
標(biāo) 記 物: Unconjugate
克隆類型: rabbit polyclonal
技術(shù)規(guī)格
|
Background: |
Nicotinic acid (NA; niacin) is converted by nicotinic acid phosphoribosyltransferase (NAPRT; EC 2.4.2.11) to NA mononucleotide (NaMN), which is then converted to NA adenine dinucleotide (NaAD), and finally to nicotinamide adenine dinucleotide (NAD), which serves as a coenzyme in cellular redox reactions and is an essential component of a variety of processes in cellular metabolism including response to stress (Hara et al., 2007). |
|
Applications: |
ELISA, IHC |
|
Name of antibody: |
NAPRT |
|
Immunogen: |
Fusion protein of human NAPRT |
|
Full name: |
nicotinate phosphoribosyltransferase |
|
Synonyms: |
NAPRT1; PP3856 |
|
SwissProt: |
Q6XQN6 |
|
ELISA Recommended dilution: |
5000-10000 |
|
IHC positive control: |
Human tonsil and Human breast cancer |
|
IHC Recommend dilution: |
50-300 |

購物車
幫助
021-54845833/15800441009
